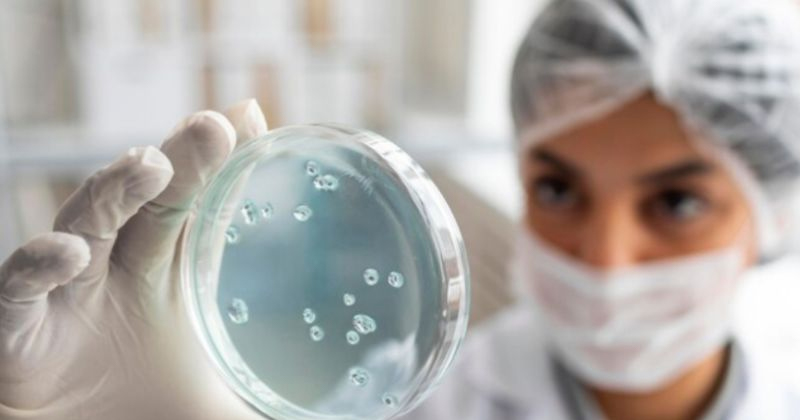

Científicos descubren nuevo virus mortal en EU
Los especialistas comentaron que el virus fue descubierto en musarañas, pequeños animales similares a los topos; hasta ahora, no se ha contagiado a seres humanos
Tarjeta Bienestar Paisano: Estos son los requisitos para los migrantes

Si los migrantes quieren tramitar algún apoyo de parte del gobierno federal será necesario presentar esta documentación.
Piden cambiar microbuses por combis

Comerciantes aseguran que las unidades de menor tamaño podrían ingresar a la zona de mercados
Sorprenden toninas a paseantes en la playa

La majestuosidad de estos seres marinos saltando fuera del agua capturó la atención de todos, quienes, desde la distancia, no dudaron en buscar la forma de capturar el momento
Banxico alerta sobre aumento en la circulación de dinero falso

Autoridades han enfatizado la necesidad de reforzar vigilancia en zonas comerciales y bancarias, donde se ha reportado una mayor circulación de billetes apócrifos
Reconoce Armando Martínez al Ejido Santa Juana en su 91 aniversario

El presidente municipal reafirmó el respaldo de su gobierno para este ejido y la zona rural de Altamira
Ofrece Mónica Villarreal servicios médicos de calidad a bajo costo a través del DIF Tampico

Ofrecen a la población en general atención médica de calidad en las instalaciones del organismo ubicadas en la zona centro
Impulsan estrategias para mejorar la gestión de residuos en Tamaulipas

Con estas iniciativas, el Gobierno del Estado busca garantizar una gestión ambiental más eficiente y aprovechar mejor los recursos municipales destinados a la recolección y disposición de residuos
Celebra Américo Villarreal acuerdo de Sheinbaum y Trump

El mandatario destacó y aplaudió el valor y la actitud enérgica de la presidenta Claudia Sheinbaum en la defensa de nuestra soberanía
Imelda Tuñón declara que quieren separarla de su hijo metiéndola a clínica de rehabilitación

Tras la polémica entre Maribel Guardia e Imelda Tuñón por la custodia de José Julián, la madre del pequeño asegura le quieren quitar al niño